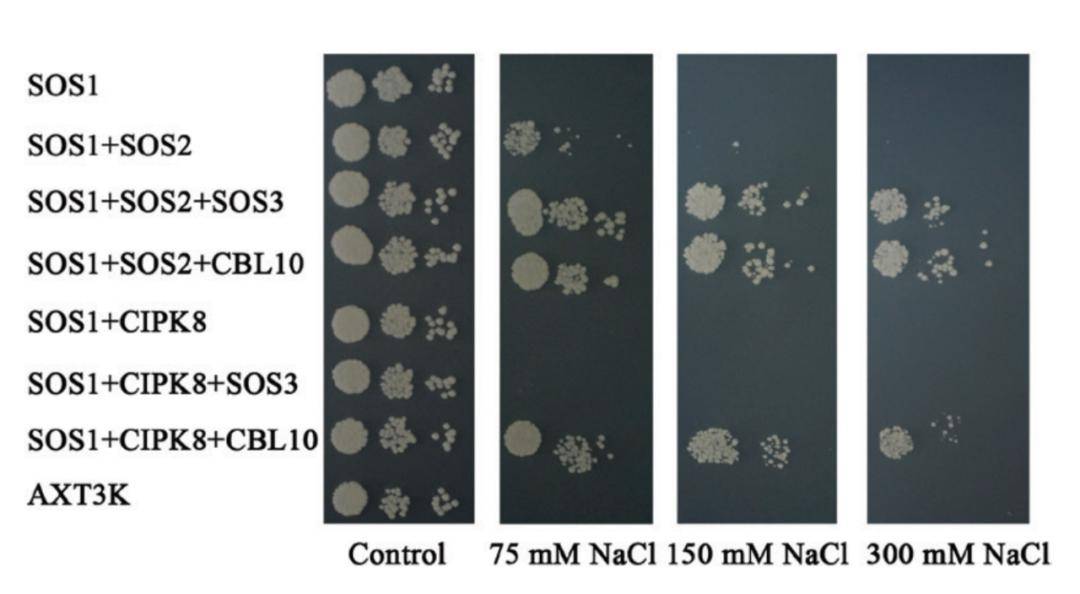
研究表明,植物排出胞质溶胶中多余na 的过程主要由na 转运蛋白完成.

细胞溶胶

第三节细胞质ppt
图片尺寸1080x810
气溶胶
图片尺寸630x280
材料理化性质的前期研究:作者通过溶胶
图片尺寸1416x1087
kp.2变异株是什么?会不会引发新一波疫情高峰
图片尺寸1320x732![细胞内铁的处理及其在铁死亡中的作用[1]一旦进入胞质溶胶,fe](https://i.ecywang.com/upload/1/img2.baidu.com/it/u=904138341,1267954391&fm=253&fmt=auto&app=138&f=JPEG?w=526&h=500)
细胞内铁的处理及其在铁死亡中的作用[1]一旦进入胞质溶胶,fe
图片尺寸1080x1026
②溶酶体对细胞内组分的利用是和膜融合后利用自身酶来降解.
图片尺寸641x427
一个细胞内结构和两个细胞外结构域组成,n端和c端均位于胞质溶胶内,暂
图片尺寸660x382
细胞代谢(cell metabolism)全面概述(1)
图片尺寸539x428
成绩按"闹"修改事件, 西安科技大学展开调查|秦风|实验|气溶胶|核聚变
图片尺寸660x371
开窗通风和空气净化器,哪个才是病毒气溶胶的克星_试验_去除率_功能
图片尺寸1080x660
新风知识科普 篇十五:从气溶胶到新风机,新风是否可以解决气溶胶扩散
图片尺寸1080x720
研究表明,植物排出胞质溶胶中多余na 的过程主要由na 转运蛋白完成.
图片尺寸1080x594
2区top刊-广中医一附院揭示网药与蛋白质组揭示小青龙汤对中性粒细胞
图片尺寸660x824
t 细胞激活服务|流式检测服务|免疫学检测实验|细胞增殖实验服务
图片尺寸660x115
中山大学附属第一医院发表的论文因图片数据重复被评议
图片尺寸660x363
前b细胞(cd19 和cd20 )起源于前b细胞(cd19 -和cd20 -),在骨髓中发育
图片尺寸660x463
病原菌代表:结核分枝杆菌
图片尺寸612x408
细胞质包含有胞质溶胶及除细胞核外的细胞器.
图片尺寸512x512
c ta肌肉横截面用h&e染色以可视化细胞核(紫色)和胞质溶胶(粉色);d
图片尺寸500x543
the innovation | 熊熊野火日益威胁着公众健康和生态
图片尺寸960x1293




![细胞内铁的处理及其在铁死亡中的作用[1]一旦进入胞质溶胶,fe](https://i.ecywang.com/upload/1/img2.baidu.com/it/u=904138341,1267954391&fm=253&fmt=auto&app=138&f=JPEG?w=526&h=500)

















![细胞内铁的处理及其在铁死亡中的作用[1]一旦进入胞质溶胶,fe](https://img-blog.csdnimg.cn/img_convert/4d9b80949e1c1a68b4120c36fe92257c.jpeg)